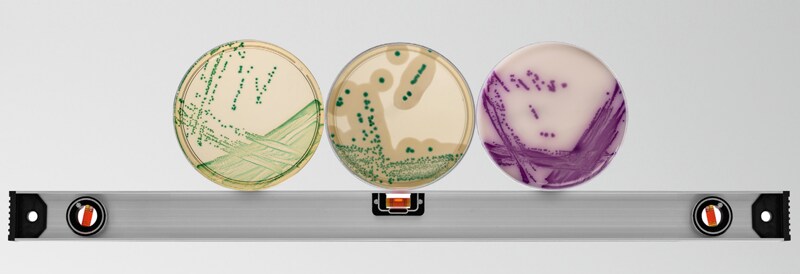

Nützliche Links
Jetzt sparen - Exklusive Angebote
Katalognummer 10473673
Katalognummer 4523608
Katalognummer 11934042
Katalognummer 13245359
Katalognummer 12942638
Katalognummer 13265339
Katalognummer 11974102
Katalognummer 11632139
Katalognummer 11790896
Katalognummer 10612592
Katalognummer 15972710
Katalognummer 11994172
Muss man haben
Katalognummer 7113093
Katalognummer 7000009
Katalognummer 10240973
Katalognummer 11974132
Katalognummer 12769090
Katalognummer 4231973
Katalognummer 10796662
Katalognummer 10544951
Vervollständigen Sie Ihre Bestellung - Tolle Angebote
Katalognummer 4842411
Katalognummer 8000185
Katalognummer 4530188
Häufig gestellte Fragen
Die Auswahl des geeigneten vorbereiteten mikrobiologischen Mediums hängt von mehreren Faktoren ab, die mit den spezifischen Anforderungen Ihres Experiments oder Ihrer Anwendung zusammenhängen. Hier sind wichtige Überlegungen, die Ihre Auswahl leiten können:
Art des Mikroorganismus:
- Bakterien: Nähragar, tryptischer Sojaagar oder Blutagar für allgemeines Bakterienwachstum
- Pilze: Sabouraud-Dextrose-Agar oder Kartoffel-Dextrose-Agar
- Spezifische Pathogene: Spezialisierte Medien wie MacConkey-Agar für gramnegative Bakterien oder Mannit-Salz-Agar für Staphylokokken
Zweck des Experiments:
- Isolation und Reinkultur: Verwenden Sie feste Medien wie Nähragar oder Blutagar, um Kolonien zu isolieren
- Anreicherung: Verwenden Sie flüssige Medien wie Nährbouillon, um die Anzahl der Mikroorganismen zu erhöhen
- Unterscheidung: Verwenden Sie differenzielle Medien wie MacConkey-Agar, um verschiedene Mikroorganismen anhand von Farbveränderungen oder anderen Reaktionen zu unterscheiden
- Selektives Wachstum: Verwenden Sie selektive Medien, die unerwünschte Mikroorganismen hemmen und gleichzeitig das Wachstum der Zielorganismen ermöglichen. Zum Beispiel Eosin-Methylenblau (EMB)-Agar für gramnegative Bakterien
Ernährungsbedürfnisse:
- Allgemeine Nährstoffanforderungen: Verwenden Sie nährstoffreiche Medien wie tryptischen Sojaagar oder -bouillon
- Anspruchsvolle Organismen: Verwenden Sie angereicherte Medien wie Blutagar oder Schokoladenagar, die zusätzliche Nährstoffe bereitstellen
Physiologische und Biochemische Tests:
- Fermentation von Kohlenhydraten: Verwenden Sie Medien wie Phenolrot-Bouillon mit spezifischen Kohlenhydraten
- Motilitätstest: Verwenden Sie halbflüssige Medien wie Motilitätsagar
- Enzymaktivität: Verwenden Sie Medien wie Stärkeagar, um die Amylaseaktivität zu testen, oder Caseinagar für die Proteaseaktivität
Umweltbedingungen:
- Aerob vs. Anaerob: Stellen Sie sicher, dass die Medien und die Inkubationsbedingungen den Sauerstoffanforderungen der Mikroorganismen entsprechen
Regulatorische und Standardprotokolle:
- Klinische und Diagnostische Labors: Befolgen Sie die standardisierten Medienanforderungen, die von Regulierungsbehörden wie der CLSI (Clinical and Laboratory Standards Institute) festgelegt wurden
Die Begriffe "Petrischale" und "Agarplatte" werden oft synonym verwendet, aber sie beziehen sich auf verschiedene Aspekte der mikrobiologischen Kulturwerkzeuge:
Petrischale:
Eine Petrischale ist eine flache, zylindrische, mit einem Deckel versehene Schale aus Glas oder Kunststoff. Sie ist ein Behälter, der verwendet wird, um Kulturmedien zu halten und Mikroorganismen zu züchten. Die Schale selbst enthält keine Medien oder Nährstoffe, wenn sie leer ist.
Agarplatte:
Eine Agarplatte ist eine Petrischale, die mit einem nährstoffreichen Agar-Medium gefüllt wurde. Agar ist eine gallertartige Substanz, die aus Algen gewonnen wird und zur Verfestigung des Nährmediums verwendet wird. Die Agarplatte dient als Wachstumsmedium, auf dem Mikroorganismen kultiviert und beobachtet werden können.
Vorbereitete mikrobiologische Medien gibt es in verschiedenen Formen, die jeweils für spezifische Zwecke entwickelt wurden. Hier sind Beispiele für verschiedene Typen:
Allzweckmedien:
- Nähragar (NA): Wird für die allgemeine Kultivierung einer Vielzahl von nicht anspruchsvollen Mikroorganismen verwendet
- Tryptic Soy Agar (TSA): Ein weiteres Allzweckmedium, das für das Wachstum einer breiten Palette von Mikroorganismen geeignet ist
Selektive Medien:
- MacConkey Agar: Selektiv für gramnegative Bakterien und differenziert zwischen Laktose-Fermentern und Nicht-Fermentern
- Mannitol-Salz-Agar (MSA): Selektiv für Staphylokokken aufgrund seiner hohen Salzkonzentration und differenziert basierend auf Mannit-Fermentation
Differenzielle Medien:
- Blutagar: Wird verwendet, um Bakterien basierend auf ihren hämolytischen Eigenschaften zu differenzieren (z.B. alpha-, beta- und gamma-Hämolyse)
- Eosin-Methylen-Blau (EMB) Agar: Differenziert zwischen Laktose-Fermentern, die dunkle Kolonien produzieren, und Nicht-Fermentern, die farblose Kolonien produzieren
Angereicherte Medien:
- Schokoladenagar: Angereichert mit lysierten roten Blutkörperchen, verwendet für das Wachstum anspruchsvoller Organismen wie Haemophilus influenzae und Neisseria-Arten
- Blutagar: Angereichert mit Vollblut zur Unterstützung des Wachstums anspruchsvoller Bakterien und zur Beobachtung der hämolytischen Aktivität
Anreicherungsmedien:
- Selenit-F-Brühe: Wird verwendet, um Salmonella-Arten aus fäkalen und anderen Proben anzureichern
- Tetrathionat-Brühe: Anreicherungsmedium für die Isolierung von Salmonella- und Shigella-Arten
Transportmedien:
- Amies Medium: Wird für den Transport klinischer Proben verwendet und erhält die Lebensfähigkeit der Pathogene, ohne deren Wachstum zu fördern